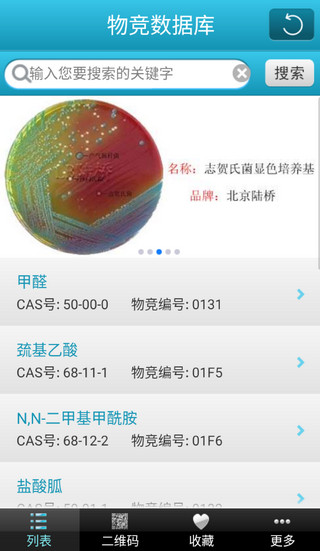
物竞数据库怎么搜索

物竞数据库是一款免费又专业的化学品信息库APP,中文界面设计让它更适合国内化学从业者使用。无论是学生、研究者还是检测机构的人员,这款工具都能帮到你。它支持中英文查询,还有CAS号、系统名等多种搜索方式,数据涵盖5万多种化学品的基础信息、物性数据、安全毒理和合成方法等内容。
我记得刚开始学化学时,常常被各种专业术语和命名规则搞糊涂,要是能有个像物竞数据库这样的工具就好了!它不仅解决了中英文差异的问题,还能直接看到参考文献和权威论文,这对学习和研究真的挺方便的。最让我喜欢的是它的离线功能,随时随地都能用。
另外,扫描二维码查询化学信息也特别实用,这种科技感很强的功能设计真的很加分。而且数据会定期更新,这对于需要前沿资料的研究者来说简直是完美的选择。如果你从事化学相关工作或学习,这款APP真的值得试试,绝对能提高效率!

物竞数据库怎么搜索
1、打开物竞化学品数据库app即可看到搜索框,支持中文、英文、系统名、CAS号、分类关键词等多种查询方式
2、使用中文搜索

3、使用元素符号/化学分子式搜索

4、使用CAS号搜索
应用功能
查询海量化学物品数据了解构成物品的化学成分信息
收集各种化学物品数据信息
化学物品合成、用途一看便知
应用特色
简单方便,包含海量数据,查询速度飞快不管是生活中的常见物品还是研究室的化学物品都能查
从分子结构到实际合成贮存用途都给你写的清清楚楚
不懂的地方可以阅读参考文献,权威论文
应用亮点
可以学到很多关于物品化学成分方面的知识打开扫描二维码功能,直接将化学信息扫出来
登陆账号即可收藏数据,再也不用反复查找
数据全面实时更新,特别适合化学行业研究者
更新日志
v3.0版本优化用户体验
修复已知bug



































共有 0条评论